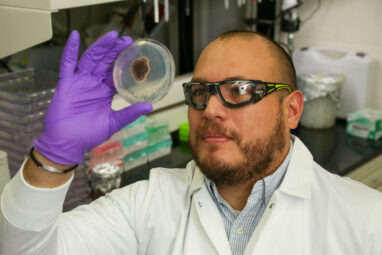

Advanced synchrotron tomography is a critical research tool, allowing scientists to explore the intricate structures of objects in extremely high...
Terahertz waves can penetrate opaque materials and provide unique spectral signatures of various chemicals, but their adoption for real-world applications...
Even if global warming were to stop completely, the volume of ice in the European Alps would fall by 34%...
Biomedical engineers at Duke University have developed a new method to improve the effectiveness of machine learning models. By pairing...
When it comes to product design, brand consistency is one key to success across product lines, managing brands’ essence and...
Scientists at Heriot-Watt University in Edinburgh, Scotland, have found a powerful new way to program optical circuits that are critical...
Researchers at Kyushu University, in collaboration with Osaka University and the Fine Ceramics Center, have developed a framework that uses...
Members of a hunter-gatherer group that lived in south-western Scandinavia during the Mesolithic era—approximately 10,000 years ago—may have been affected...
Monterey Bay Aquarium researchers strengthen the link between sea otters and long-term health of California kelp forests in a new...
What is the likelihood of dying in a plane crash? According to a 2022 report released by the International Air...
A new computational framework created by Oak Ridge National Laboratory researchers is accelerating their understanding of who’s in, who’s out,...
The image spoke for itself. University at Buffalo computer scientist and deepfake expert Siwei Lyu created a photo collage out...